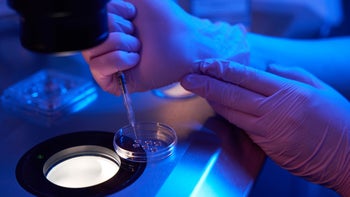
Reproductive health: closeup injecting eggs onto petri plate 1732050393

Skip to main content
Veneta Lusk is a personal finance and healthcare writer with 15 years of experience. She holds a bachelor of arts in journalism from the University of North Carolina at Chapel Hill. Her writing and financial expertise have been featured in such publications as Business Insider, MSN Money, Yahoo! Finance, Go Banking Rates, and Debt.com.
Prior to becoming a freelance writer, Veneta worked on the marketing communications team for one of the largest safety net hospitals in the U.S. She loves empowering people to get smart about their health and their money.